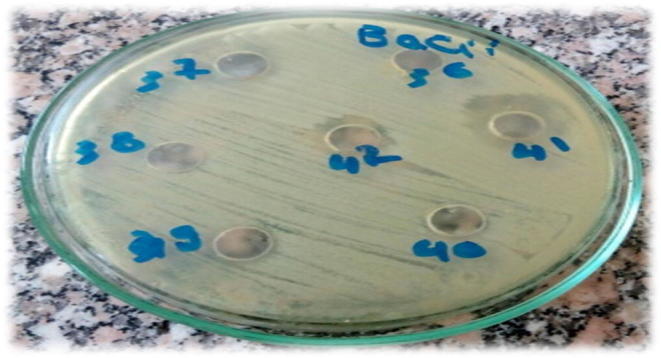
Fig. 2

Abstract
Emergence of multidrug resistant bacteria has made the search for novel bioactive compounds from natural and unexplored habitats a necessity. Actinobacteria have important bioactive substances. The present study investigated antimicrobial activity of Actinobacteria isolated from soil samples of Egypt. One hundred samples were collected from agricultural farming soil of different governorates. Twelve isolates have produced activity against the tested microorganisms (S. aureus, Bacillus cereus, E. coli, K. pneumoniae, P. aeruginosa, S. Typhi, C. albicans, A. niger and A. flavus). By VITEK 2 system version: 07.01 the 12 isolates were identified as Kocuria kristinae, Kocuria rosea, Streptomyces griseus, Streptomyces flaveolus and Actinobacteria. Using ethyl acetate extraction method the isolates culture’s supernatants were tested by diffusion method against indicator microorganisms. These results indicate that Actinobacteria isolated from Egypt farms could be sources of antimicrobial bioactive substances.
Keywords: Actinobacteria, Antibacteria, Antifungal, Kocuria, Soil, Streptomyces
1. Introduction
Bacteria have so far been the most promising resource for antibiotics in the past decades and will undoubtedly remain an important resource of innovative bioactive natural products in the future. Approximately 45% of bioactive compounds obtained from microbes were produced by Actinomycetes (Berdy, 2005). Actinomycetes remain the most economically and biotechnologically useful microbes, producing 80% of the world’s antibiotics, mostly from the genera Streptomyces and Micromonospora (Pandey et al., 2004).
Many vitamins, antibiotics, enzymes and siderophores obtained by Actinomycetes have pharmaceutical, veterinary, agricultural and clinical applications (Koehn and Carter, 2005, Kekuda et al., 2010, Naine et al., 2011), in addition to antitumor and wound healing properties (Janardhan et al., 2012, Jiao et al., 2013).
Since the discovery of antibiotics, bacterial resistance to these drugs has continued to evolve. Thus, we are witnessing more and more multiresistant bacteria that pose a serious public health problem. The present investigation aimed to study antimicrobial activity of Actinobacteria isolated from soil samples of Egypt.
2. Materials and methods
2.1. Sample processing and isolation of Actinomycetes
One hundred soil samples collected from Egyptian governorates were dried in room temperature for 24 h then ground and sterilized as recorded by Saadoun et al. (1999). The samples were inoculated on actinomycetes isolation agar and incubated at 30 °C for 5–7 days. The Gram positive mycelial shape bacilli were identified (Holt et al., 1994; Anderson and Wellington, 2001).
2.2. Screening of antimicrobial activities of pure isolates
Preliminary screening for antibiotic activity of the isolates was done by using perpendicular streak method on Mueller Hinton agar medium (Shomura et al., 1980).
2.3. The indicator organisms
Gram Positive bacteria: S. aureus (NCTC 7447 0.0), Bacillus cereus, Gram Negative: E. coli (NCTC 10416 0.0), Klebsiella pneumoniae (NCIMB 9111 0.0), P. aeruginosa (ATCC 10145 0.0), Salmonella Typhi, Candida albicans, A. niger and A. flavus were kindly supplied from Department of Microbiology Faculty of Veterinary Medicine Cairo University.
2.4. Extraction of bioactive substances
The potential Actinobacteria was subjected to submerged state fermentation method to produce crude extracts (Westley et al., 1979). Antimicrobial activity of the crude extracts was estimated among the indicator microorganisms,
3. Results
3.1. Occurrence of Actinobacteria among the examined soil samples
As shown in Table 1 a total of 12 isolates out of 100 soil samples were identified as Actinobacteria. All isolates were Gram positive aerobic bacilli slow growing small white to creamy colonies Fig. 1. By VITEK 2 system version: 07.01 the isolates were identified as Kocuria kristinae (1), Kocuria rosea (3), Streptomyces griseus (4), Streptomyces flaveolus (2) and Actinobacteria (2).
Table 1.
Positive number of Actinobacteria among the examined soil samples.
| Governorates | No. of samples | No. of positive samples |
|
|---|---|---|---|
| No. | % | ||
| Alexandria | 3 | – | – |
| El Gharbia | 15 | 2 | 13.3 |
| El Monofia | 55 | 8 | 14.5 |
| El Sharkia | 5 | – | – |
| El Menia | 2 | – | – |
| El Behira | 5 | – | – |
| El Dakahlia | 4 | – | – |
| Kafr El shak | 5 | 2 | 40 |
| Matrouh | 6 | – | – |
| Total | 100 | 12 | 12 |
Fig. 1.
Streak-plating technique to determine the antibacterial activity among the isolates. Inhibitory action of Actinobacteria isolated from soil samples against the indicator bacteria.
3.2. Antimicrobial activities of the isolates
The isolates were screened for their antibacterial activity on Mueller Hinton agar medium using streak-plating technique Fig. 2. The zone of inhibition among the Actinobacteria isolates against the indicator microorganisms was recorded as shown in Table 2, Table 3.
Fig. 2.
The inhibition zone of the Actinobacteria isolated from soil samples against the indicator bacteria for both Gram positive and negative.
Table 2.
Average inhibition zone of the Actinobacteria isolated from soil samples against the indicator bacteria.
| No | Spp. | Zone of inhibition (in mm) |
|||||
|---|---|---|---|---|---|---|---|
| Gram positive bacteria |
Gram negative bacteria |
||||||
| S. aureus | B. cereus | E. coli | P. aeruginosa | K. pneumoniae | S. Typhi | ||
| 1 | Kocuria kristinae | – | 10.2 | – | 6 | – | 8 |
| 2 | Kocuria rosea | 5.4 | 8 | – | 8 | – | – |
| 3 | Streptomyces griseus | – | – | – | – | – | 6.7 |
| 4 | Streptomyces griseus | – | 8.2 | – | – | – | 3.5 |
| 5 | Kocuria rosea | 7.4 | 3.8 | – | – | – | 6 |
| 6 | Streptomyces griseus | – | 9.2 | – | – | – | – |
| 7 | Streptomyces griseus | – | 5.6 | – | – | – | – |
| 8 | Streptomyces flaveolus | – | 6.3 | – | – | – | – |
| 9 | Kocuria rosea | – | 7.8 | – | – | – | – |
| 10 | Actinomycetes | – | 4.2 | – | – | – | – |
| 11 | Streptomyces flaveolus | 6.8 | 7.1 | – | – | 2.5 | – |
| 12 | Actinomycetes | 9.1 | 8 | – | – | – | – |
Table 3.
Average inhibition zone of the isolates against the indicator fungi.
| No | Spp. | Zone of inhibition (in mm) |
||
|---|---|---|---|---|
| Candida albicans | A. niger | A. flavus | ||
| 1 | K. kristinae | – | 3.7 | – |
| 2 | K. rosea | 5.4 | – | – |
| 3 | S. griseus | – | – | 3.5 |
| 6 | S. griseus | 5 | 2.9 | – |
| 8 | S. flaveolus | 4.2 | – | – |
| 9 | K. rosea | – | – | 2 |
| 12 | Actinomycetes | 3 | – | – |
4. Discussion
Actinomycetes are widely distributed in the nature and have the ability to produce many biologically active substances like antibacterial, antifungal, antiviral, anti-parasitic, herbicides, pesticides, antioxidant and antitumor. The present study was performed to study the antimicrobial activity of Actinobacteria isolated from soil. Actinomycetes have provided many industrially important bioactive compounds (Kumar and Jadeja, 2016). One hundred farming soil samples collected from Egyptian Governments were investigated. The samples were growing on Actinomycetes isolation agar for isolation and identification of Actinobacteria. All isolates (n = 12) were Gram positive aerobic slow growing bacteria (Anderson and Wellington, 2001) with earthy odor. The isolates were identified as Kocuria kristinae, Kocuria rosea, Streptomyces griseus, Streptomyces flaveolus and Actinomycetes using VITEK 2 system.
The twelve isolates exhibited a broad spectrum of antimicrobial activity. Twenty isolates (13.30%) out of 150 Actinomycetes examined by Rahman et al. (2011) had antimicrobial activity against the test microorganisms. Also Dehnad et al. (2010) investigated the bioactivity of Streptomyces isolates from Iran. Arifuzzaman et al. (2010) recorded 20 isolates (36.36%) showed activity against the test bacteria.
These identified isolates showed antimicrobial activity against the test organism and the range of inhibition zones was between 2.5 and 10.2 mm. Strain 1 showed the largest inhibition zone in B. cereus, while strain 11 was weakly active, and showed the least inhibition zone in Klebsiella pneumoniae. All strain could not inhibit E. coli, all strain showed moderate to high activity in B. cereus. One strain only showed inhibition zone in Klebsiella pneumonia. Gram-negative strains were highly resistant and were consistent with the known susceptibility differences among the target organisms (Basilio et al., 2003).
Also, 4 isolates had activity against Candida albicans, 2 against A. niger and 2 against A. flavus. Out of 287 actinomycetes166 isolates were found antagonistic to Candida albicans, while 164, 134 and 132 actinomycetes showed antagonistic properties against A. niger, M. gypseum and Trichophyton sp., respectively (Jain and Jain, 2003).
The actinomycete isolated by Dharumaduari et al. (2008) had antimicrobial activity.
Ouhdouch et al. (2001) recorded that 32 out of 320 actinomycete strains isolated from several Moroccan habitats showed strong activity against yeast, moulds and bacteria.
We can conclude that the soil samples are rich source of Actinobacteria which exhibit a wide spectrum antimicrobial agent. Further investigations are needed to identify the strain at molecular level and to determine the active metabolites of these isolates.
5. Conclusion
We can conclude that the soil samples are rich source of Actinobacteria which exhibit a wide spectrum antimicrobial agent.
Acknowledgment
The authors extend their appreciation to the Deanship of Scientific Research at King Saud University for funding the work through the research group project No.: RG-162.
Footnotes
Peer review under responsibility of King Saud University.
References
- Anderson A.S., Wellington E.M.H. The taxonomy of Streptomyces and related genera. Int. J. Syst. Evol. Microbiol. 2001;51(3):797–814. doi: 10.1099/00207713-51-3-797. [DOI] [PubMed] [Google Scholar]
- Arifuzzaman M., Khatun M.R., Rahman H. Isolation and screening of actinomycetes from Sundarbans soil for antibacterial activity. Afri. J. Biotech. 2010;9(29):4615–4619. [Google Scholar]
- Basilio A., Gonzalez I., Vicente M.F., Gorrochategui J., Cabello A., Gonzalez A., Genilloud O. Patterns of antimicrobial activities from soil actinomycetes isolated under different condition of pH and salinity. J. Appl. Microbiol. 2003;95:814–823. doi: 10.1046/j.1365-2672.2003.02049.x. [DOI] [PubMed] [Google Scholar]
- Berdy J. Bioactive microbial metabolites: a personal view. J. Antibiot. 2005;58(1):1–26. doi: 10.1038/ja.2005.1. [DOI] [PubMed] [Google Scholar]
- Dehnad A., Parsa L., Bakhshi R., Soofiani S.A., Mokhtarzadeh A. Investigation antibacterial activity of Streptomycetes isolates from soil samples, West of Iran. Afri. J. Microbiol. Res. 2010;4(14):1542–1549. [Google Scholar]
- Dharumaduari D., Nooruddin T., Annamalai P. An antifungal compound: 4′phenyl-1-napthyl- phenyl acetamide from Streptomyces species universitatis series. Med. Biol. 2008;15(1):7–12. [Google Scholar]
- Holt, J.G., Krieg, N.R., Sneath, P.H.A., Staley, J.T., Williams, S.T., 1994. Bergey’s Manual of Determination. Bacteriol. 9th ed.
- Jain P.K., Jain P.C. Antifungal activity of some Actinomycetes isolated from various habitats. Hindustan Antibiot. Bull. 2003;45–46(1–4):5–10. [PubMed] [Google Scholar]
- Janardhan A., Praveen K.A., Reddi P.M., Sai G.D., Narasimha G. Wound healing property of bioactive compound from Actinomycetes. Der Pharm. Sin. 2012;3(5):542–545. [Google Scholar]
- Jiao W., Zhang F., Zhao X., Hu J., Suh J.W. A novel alkaloid from marine-derived Actinomycete Streptomyces xinghaiensis with broad-spectrum antibacterial and cytotoxic activities. PLoS ONE. 2013;8(10):e75994. doi: 10.1371/journal.pone.0075994. [DOI] [PMC free article] [PubMed] [Google Scholar] [Retracted]
- Kekuda T.R.P., Shobha K.S., Onkarappa R. Fascinating diversity and potent biological activities of Actinomycetes metabolites. J. Pharm. Res. 2010;3:250–256. [Google Scholar]
- Koehn F.E., Carter G.T. The evolving role of natural products in drug discovery. Nat. Rev. Drug Discov. 2005;4:206–220. doi: 10.1038/nrd1657. [DOI] [PubMed] [Google Scholar]
- Kumar R.R., Jadeja V.J. Isolation of Actinomycetes: a complete approach. Int. J. Curr. Microbiol. Appl. Sci. 2016;5(5):606–618. [Google Scholar]
- Naine J., Srinivasan M.V., Devi S.C. Novel anticancer compounds from marine Actinomycetes: a review. J. Pharm. Res. 2011;4:1285–1287. [Google Scholar]
- Ouhdouch Y., Barakate M., Finance C. Actinomycetes of Moroccan habitats: isolation and screening for antifungal activities. Eur. J. Soil. Biol. 2001;37:69–74. [Google Scholar]
- Pandey B., Ghimire P., Agrawal V.P. International Conference on the Great Himalayas: Climate, Health, Ecology, Management and Conservation, Kathmandu. Organized by Kathmandu University and the Aquatic Ecosystem Health and Management Society; Canada: 2004. [Google Scholar]
- Rahman A., Islam M.Z., Islam A.U. Antibacterial activities of Actinomycete isolates collected from soils of Rajshahi, Bangladesh. Biotechnol. Res. Int. 2011:6. doi: 10.4061/2011/857925. Article ID 857925. [DOI] [PMC free article] [PubMed] [Google Scholar]
- Saadoun I., Hameed K.M., Moussauui A. Characterization and analysis of antibiotic activity of some aquatic Actinomycetes. Microbiology. 1999;99(394):173–179. [PubMed] [Google Scholar]
- Shomura T., Omoto S.M., Ohba K., Ogino H. SF-1961, a new antibiotic related to bleomycin. J. Antibiot. 1980;33(11):1243–1248. doi: 10.7164/antibiotics.33.1243. [DOI] [PubMed] [Google Scholar]
- Westley J.W., Evans R.H., Sello L.H., Troupe N., Liu C.M., Blount J.F. Isolation and characterization of antibiotic X-14547A, a novel monocarboxylic acid ionophore produced by Streptomyces antibiotics NRRL 8167. J. Antibiot. 1979;32(2):100–107. doi: 10.7164/antibiotics.32.100. [DOI] [PubMed] [Google Scholar]

